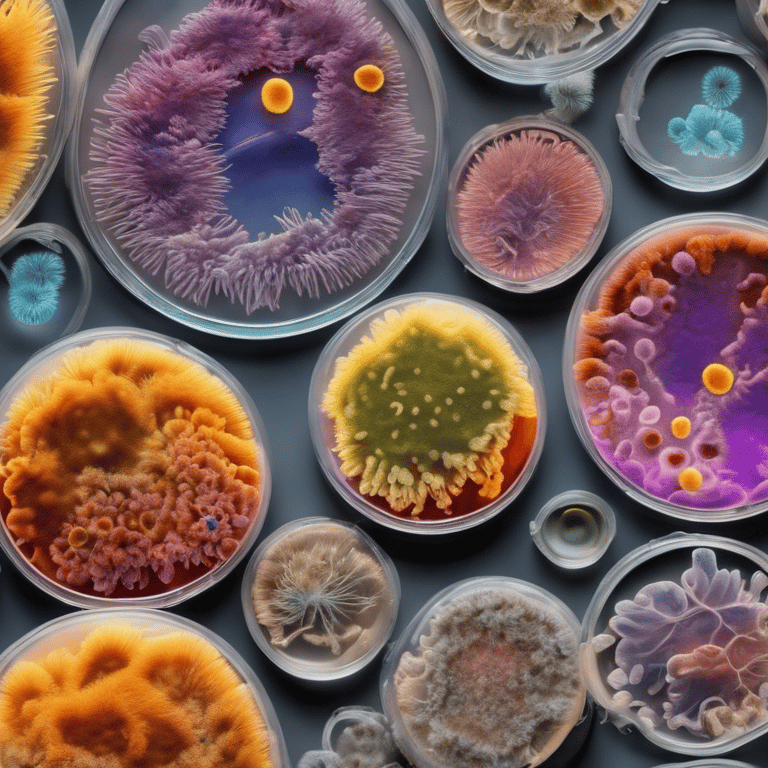
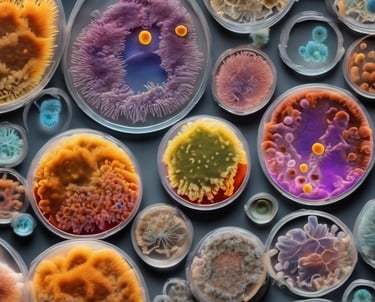

Nasmille L. Larke-Mejía
I am an MSCA postdoctoral fellow working on the μ-Arctic project, focused on microbial isoprene cycling in the Arctic and based at the Center for Volatile Interactions (VOLT) at the University of Copenhagen, Denmark. I completed my PhD and research placement at the University of East Anglia, United Kingdom, where my work centered on bacterial degradation of isoprene. I also held a postdoctoral fellowship with the UKRI-funded GROW Colombia project, where I studied soil health in sugarcane plantations and investigated the fungal phytopathogen Mycena citricolor. My ongoing research aims to deepen our understanding of microbial processes across different environments and their implications for climate change and ecosystem health.
Alongside my research career, I have developed a strong passion for science communication, public engagement, and the dissemination of scientific knowledge through accessible writing and editorial work.


Research Experience
Marie Skłodowska Curie Actions postdoctoral fellow (μ-Arctic project)

Postdoctoral Research Fellow (UKRI-funded GROW Colombia project)
June 2022 - September 2024
Postdoctoral Researcher (maternity cover and BARTS charity project)
May 2019 - December 2021
October 2024 - September 2026
Microbes and the Food Chain, Quadram Institute Biosciences, Norwich, UK
Organisms and Ecosystems, Earlham Institute, Norwich, UK
Research Technician/Lab Manager (ERC-funded IsoMet project)
ELSA lab, Dept. Environmental Sciences. University of East Anglia, Norwich, UK.
July 2017 - August 2022
January 2015 - December 2018
ELSA lab, Dept. Environmental Sciences. University of East Anglia, Norwich, UK
VOLT center, Dept. Biology, University of Copenhagen, DK
PhD student (Colombian government-funded scholarship)
‘Meet the Scientists’ at VOLT
I’m currently diving into an exciting project called μ-Arctic, where I’m exploring isoprene cycling and microbial communities of Arctic plants.
To learn more, watch this video!
#emission #isoprene #arctic #plants #microbiology #degradation
YouTube video published 19 Nov 2024

Publications
Diaz, Maria; Aird, Heather; Le Viet, Thanh; Gutiérrez, Ana Victoria; Larke-Mejia, Nasmille; Omelchenko, Oleksii; Moragues-Solanas, Louis; Fritscher, Joachim; Som, Nicole; McLauchlin, Jim; Hildebrand, Falk; Jørgensen, Frieda; Gilmour, Matthew. Microbial composition and dynamics in environmental samples from a ready-to-eat food production facility with a long-term colonization of Listeria monocytogenes. Food Microbiology, Volume 125, 2025, 104649, ISSN 0740-0020, https://doi.org/10.1016/j.fm.2024.104649.
Almog, G., Rubin-Blum, M., Murrell, C., Vigderovich, H., Eckert, W., Larke-Mejia, N. L., and Sivan, O. Survival strategies of aerobic methanotrophs under hypoxia in methanogenic lake sediments. Environmental Microbiome 19, 44 (2024). https://doi.org/10.1186/s40793-024-00586-1
Larke-Mejía, NL, Carrión, O., Crombie, A.T., McGenity, T.J. and Murrell, J. C. Sphingopyxis sp. strain OPL5, an isoprene-degrading bacterium from the Sphingomonadaceae family isolated from oil palm leaves. Microorganisms 2020 (10), 1557. DOI: 10.3390/microorganisms8101557
Gibson, L.; Larke-Mejía, N.L.; Murrell, J.C. Complete genome of isoprene degrading Nocardioides sp. WS12. Microorganisms 2020, 8, 889. DOI: 10.3390/microorganisms8060889
Dawson, R.A.; Larke-Mejía, N.L.; Crombie, A.T.; Ul Haque, M.F.; Murrell, J.C. Isoprene Oxidation by the Gram-Negative Model bacterium Variovorax sp. WS11. Microorganisms 2020, 8, 349. DOI: 10.3390/microorganisms8030349
Larke-Mejía NL, Crombie AT, Pratscher J, McGenity TJ and Murrell JC (2019) Novel isoprene-degrading Proteobacteria from soil and leaves identified by cultivation and metagenomics analysis of stable isotope probing experiments. Front. Microbiol. 10:2700. doi: 10.3389/fmicb.2019.02700
Carrión, O., Larke-Mejía, N.L., Gibson, L. et al. Gene probing reveals the widespread distribution, diversity, and abundance of isoprene-degrading bacteria in the environment. Microbiome 6, 219 (2018). https://doi.org/10.1186/s40168-018-0607-0
Crombie, A.T., Larke-Mejia, N.L., Emery, H., Dawson, R., Pratscher, J., Murphy, G.P., McGenity, T.J. and Murrell, J.C. (2018) Poplar phyllosphere harbors disparate isoprene-degrading bacteria. Proceedings of the National Academy of Science (USA), 115(51), 13081-13086. doi:10.1073/pnas.1812668115.
Crombie A.T., Mejia-Florez N.L., McGenity T.J., Murrell J.C. (2018) Genetics and Ecology of Isoprene Degradation. In: Rojo F. (eds) Aerobic Utilization of Hydrocarbons, Oils and Lipids. Handbook of Hydrocarbon and Lipid Microbiology. Springer, Cham.
Rachael E. Antwis, Sarah M. Griffiths, Xavier A. Harrison, Paz Aranega-Bou, Andres Arce, Aimee S. Bettridge, Francesca L. Brailsford, Alexandre de Menezes, Andrew Devaynes,Kristian M. Forbes, Ellen L. Fry, Ian Goodhead, Erin Haskell, Chloe Heys, Chloe James, Sarah R. Johnston, Gillian R. Lewis, Zenobia Lewis, Michael C. Macey, Alan McCarthy, James E. McDonald, Nasmille L. Mejia-Florez, David O’Brien, Chlo´eOrland, Marco Pautasso, William D. K. Reid, Heather A. Robinson, Kenneth Wilson and William J. Sutherland. Fifty important research questions in microbial ecology. FEMS Microbiol Ecology, 2017, Vol. 93, No. 5. doi: 10.1093/femsec/fix044
Funding
Main organizations that have funded my scholarships, postdocs and fellowships








Nasmille Larke-Mejía Research
Exploring microbes' roles in environmental sustainability.
CONTACT ME:
© 2024. All rights reserved.
info@nasmillelarkemejia.com
Disclaimer: Some images and text on this website, including proofreading, have been created or refined using AI tools. For inquiries or further information, please contact me.